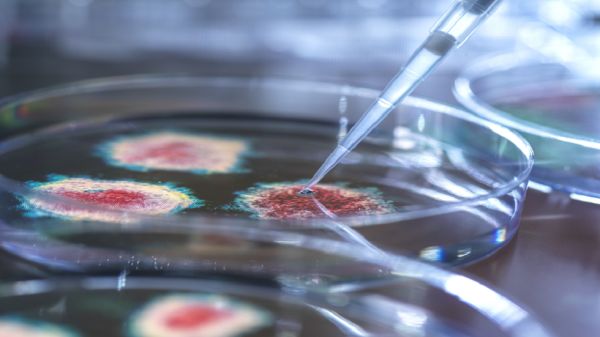
news

البحث عن: البشري
"المسخ البشري".. حين يتحدث الغرور بلسان وكيل الإعلام الحوثي
خاص-النقار القيادي في جماعة أنصار الله (الحوثيين) أحمد مطهر الشامي يسمح لنفسه إطلاق أوصاف تتعدى مسألة الاختلاف الفكري مع شخص ما، ليصفه بكل عنجهية وكبر بـ"المسخ
هل تواجه البشرية "تهديدا وجوديا"؟
تطور متسارع للتكنولوجيا التخريبية، وتصاعد متواصل للحروب والتهديدات النووية، وسط تغيرات مناخية غير مسبوقة بكوكب الأرض، عوامل تجعل البشرية أقرب إلى "نهاية العالم" أكثر من أي
الخبراء يكشفون عن فيروس يهدد البشرية
يقول كبار علماء الفيروسات، إن الوباء الجديد يمكن أن ينشأ من مرض، يبلغ معدل الوفيات فيه 40%، في غضون عقدين فقط، محذرين من أن "كوفيد" قد
أكثر الأمراض فتكًا في تاريخ البشرية
حذّر علماء من انتشار فيروس جديد بعد فيروس كورونا يعرلف بـ "Nipah"، مؤكدين أنه قد يكون أكثر الأمراض المعدية فتكاً في تاريخ البشرية.
"جماجم محطمة" تكشف تطور العنف البشري
كشف تقرير نشرته صحيفة "الغارديان" البريطانية كيف تطور العنف بين الأشخاص في المجتمعات البشرية المبكرة، وفقا لتحليل الجماجم والعظام البشرية المحطمة. وتعود الجماجم والعظام - من
دراسة : الاصوات البشرية تخيف الحيوانات أكثر من زئير الاسد
توصلت دراسة علمية حديثة الى أن الحيوانات تخشى أصوات البشر، أكثر من زئير الاسد . وكشفت الدراسة في جنوب أفريقيا أن العلماء استخدموا تسجيلات
قارة عملاقة تهدد البشرية بتغيرات "مرعبة"
أشارت دراسة جديدة إلى أن "قارة عملاقة" جديدة قد تتشكل نتيجة التغيرات المناخية القاسية يمكن أن تقضي على البشر وتجعل الأرض غير صالحة للسكن. باستخدام نماذج
الساعة واليوم والشهر الأثر فتكا بالبشرية
مثلما تساعد "ساعة الجسم" على تحديد وقت الاستيقاظ والنوم، فإنها تؤثر أيضا على الوقت الذي يرجح أن يموت فيه الشخص، وفقا للعلماء. وأظهرت دراسات مختلفة أن
سيناريوهات مخيفة للذكاء الاصطناعي تهدد "إبادة الكائن البشري"
يطلق خبراء في مجال التكنولوجيا وتقنيات الذكاء الاصطناعي تحذيرات متتالية وسط مخاوف متزايدة من تهديد تلك الأنظمة على البشر مستقبلا، بينما يكشف مختصون لموقع "الحرة"
خبراء يحذرون : الذكاء الصناعي قد يقضي على البشرية
حذرت مجموعة من كبار رجال الأعمال والخبراء، من بينهم مبتكر برنامج «ChatGPT»، سام التمان، في بيان نُشر على الإنترنت، الثلاثاء، من أن صعود الذكاء الاصطناعي ينطوي